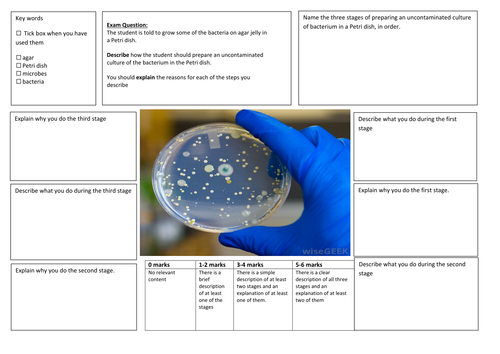
docx, 89.46 KB

This writing frame is used to help pupils practice with their extended writing questions in Science. It uses smaller steps and leading questions for pupils to be able to answer the large question that they would see in the exam. The frame include keywords that the pupils should use in their answer, a success criteria (directly from the mark scheme) and a picture in the center, either from the question itself or as a visual prompt. This is really useful for all pupils and ticks that literacy box!
Something went wrong, please try again later.
This resource hasn't been reviewed yet
To ensure quality for our reviews, only customers who have purchased this resource can review it
Report this resourceto let us know if it violates our terms and conditions.
Our customer service team will review your report and will be in touch.
£1.00
